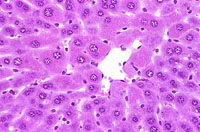
hyaline change

The Digitized Atlas of Mouse Liver Lesions

Much of the work carried out by DTT is in support of the National Toxicology Program (NTP), an interagency partnership of the Food and Drug Administration, National Institute for Occupational Safety and Health, and NIEHS.
Visit the NTP WebsiteCentrilobular hepatocytes have alterations in their cytoplasm characterized by increased eosinophilia with a fine to coarse flocculent texture. In some situation the appearance may be more homogeneous. The terminology that might be used for this change includes hyaline change, hyaline degeneration, or cytoplasmic alteration. If the latter term is used, the change must be adequately described in a pathology narrative since the term cytoplasmic alteration has different connotations to different individuals.